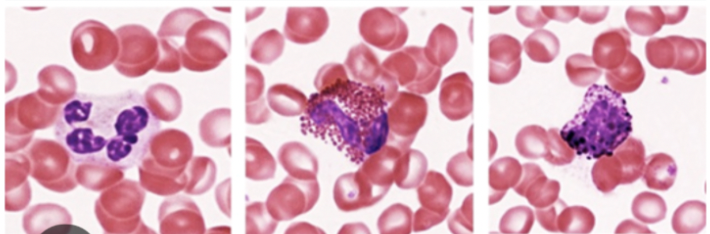
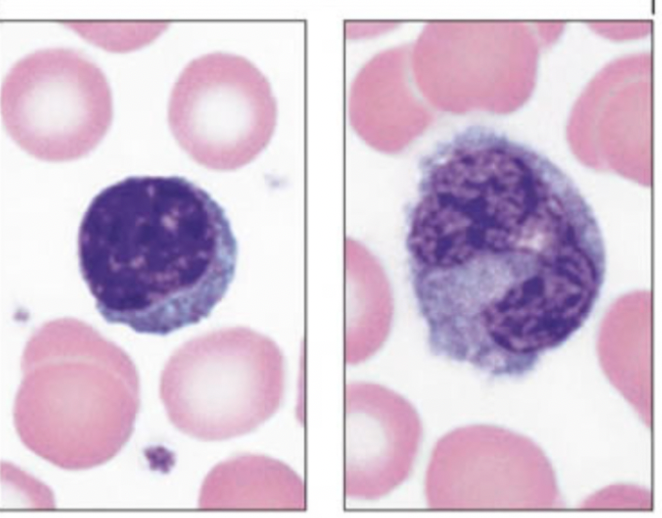
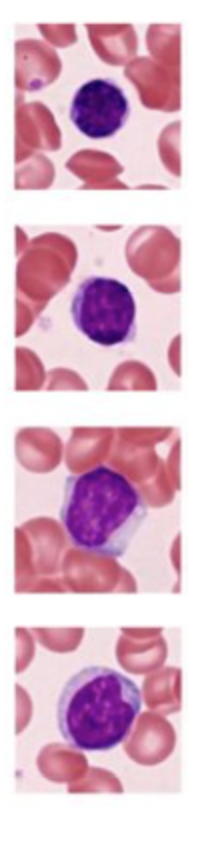
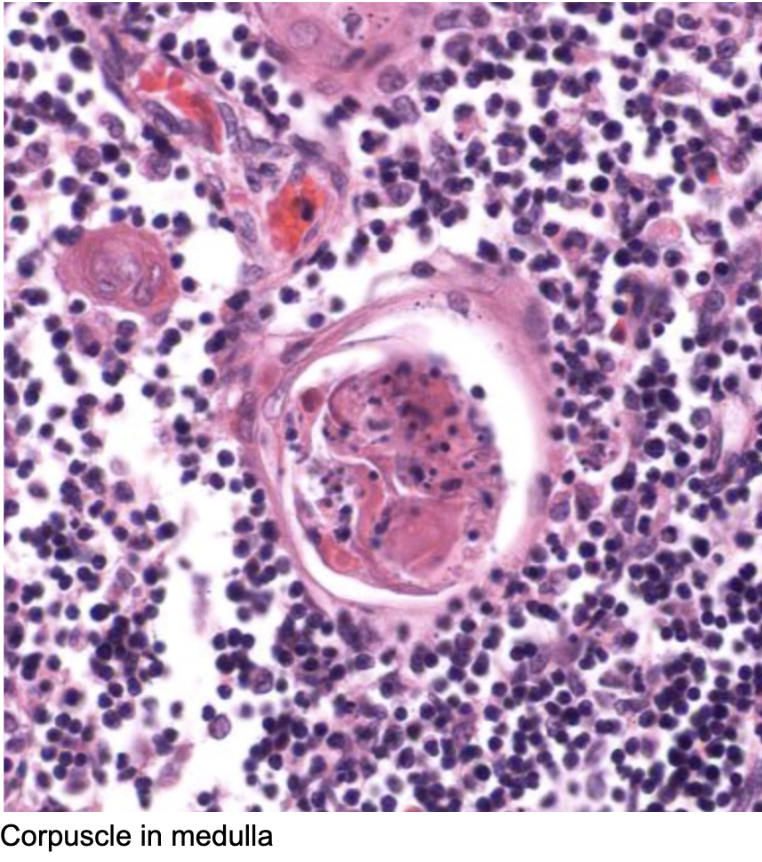
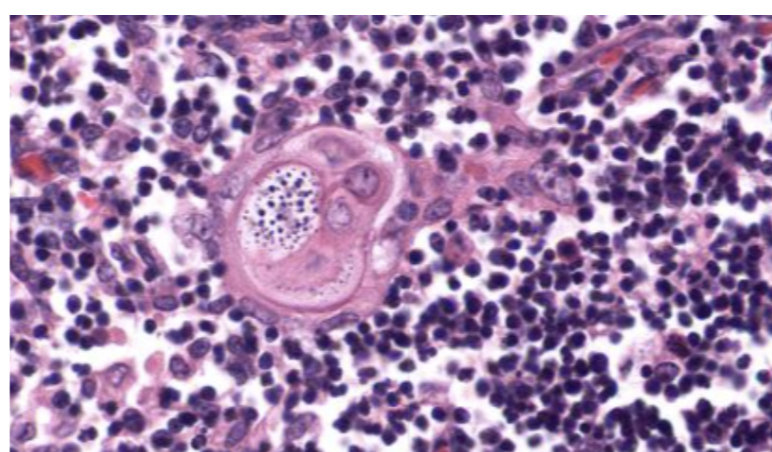
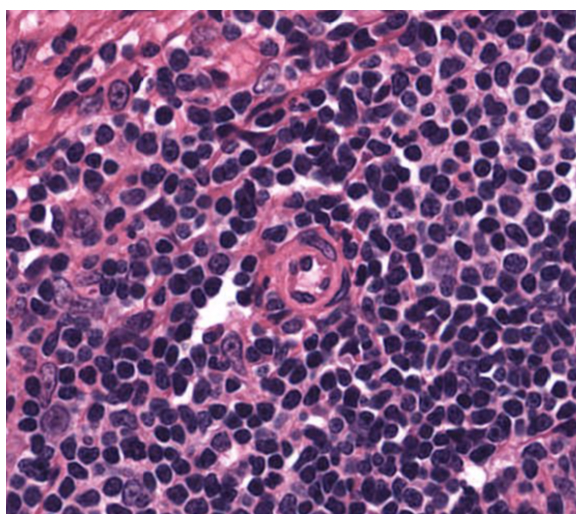

Lab Practical 3
1/116
There's no tags or description
Looks like no tags are added yet.
Name | Mastery | Learn | Test | Matching | Spaced | Call with Kai |
|---|
No analytics yet
Send a link to your students to track their progress
117 Terms
3 basic layers of veins, arteries, and capillaries
Tunica Intima: inner most layer of simple squamous epit. supported by basal lamina and CT
Tunica Media: varying amounts of smooth muscle + elastic tissues. nonexistent -millimeters thick
Tunica adventitia: Outer layer composed of CT and varies in thickness.
Veins
Carry blood away from the heart
thicker walls than veins
Composed of elastic tissue and smooth muscle tissue
Elastic arteries and muscular arteries
Veins:
Passive component, carrying blood back to the heart
thinner walls (tend to collapse
Blood composition
CT
plasma made of albumin, globulin, and fibrinogen
Erythrocytes vs Platelets
RBCs most vertebrates have no nuclei
Platelets disk-like cell fragments circulating in blood
Leukocytes
White blood cells = leukocyte
nucleated cells
can move from blood to tissue
Classification 1:
Multi-lobed nucleus and granules (granulocytes)
neutrophils, eosinophils, basophils
Classification 2:
lack specific granules and contain a round or indented nucleus
agranulocytes (lymphocytes and monocytes)
Elastic Arteries
Notable features:
found in areas of high blood flow (aorta, pulmonary artery)
In the aorta, tunica media is thick and has lots of elastic fibers
Vaso Vasorum: special group BV that provide nutrition to walls of arteries (small BV in tunica adventitia)


Elastic artery

Vasa Vasorum (large elastic arteries) :
Tiny branches of the artery/BV that provide nutrients to elastic arteries
Also visible as small BV in tunica adventitia
Pointer at Vaso Vasorum in tunica media left, and tunica adventitia right


Aorta, elastic artery
3 Layers:
Tunica intima (inner layer) SS endo lining

Tunica Media (eosinophilic)

Elastic lamellae (diffusion can work through them)
Nuclei in between lamellae (modified smooth muscle cells, secrete ECM)
Tunica adventitia (mostly CT)


Aorta, elastic artery
IEL = internal elastic lamellae

mucsular artery

WAVY TUNICA INTIMA
Less elastic lamellae more smooth muscle cells
Muscular Arteries:
Thick walls, tunica media are concentrated in smooth muscle
Tunica intima has internal elastic membrane (elastic fibers), separating from tunica media
External elastic membrane separating tunica media from tunica adventitia, more diffused than internal elastic membrane
WAVY TUNICA INTIMA
Less elastic lamellae more smooth muscle cells

WAVY TUNICA INTIMA
Less elastic lamellae more smooth muscle cells

Muscular artery:
Well developed internal elastic lamellae, causing waviness of tunica intima
Well developed internal elastic lamellae, causing waviness of tunica intima

Muscular artery
Darker brown = internal elastic lamellae
muscular artery on left, Vein on right

muscular artery and medium vein

vein

medium vein

Arteroilles:
|

arteriole and venule (arteriole bottom)

arteriole and venule

arteriole and venule


Capillaries are?
Smallest element of circulatory system
Wide enough for 1 RBC (nearly impossible to see in cross section)
Form beds that connect between the arterial and venous systems
SS epithelial layer
3 types of capillaries:
Continuous:
Continuous epithelium and basal lamina
Less permeable
CT, muscles, and CNS
Fenestrated:
Continuous epithelium and basal lamina
Gaps between endothelial cells
Intestine, endocrine glands, glomerulus
Discontinuous (sinusoids):
Gaps in basement membrane and epithelium
High permeability for water + water sol mlcls + proteins
Larger and more irregular lumen
Appear as small irregular spaces within tissue
Liver, spleen, bone marrow

capillary network
Venules are?
Venules:
Smallest veins
Postcapillary venules
Formed when capillaries join together, appear like continuous capillaries
Receive blood from capillaries
Only have tunica intima
Muscular venules
1-3 layers of smooth muscle cells in tunica media
Veins and venules often travel together

Medium veins have?
Thin layer of smooth muscle.
tunica adventitia (may have vaso vasorum)
Many have flap valves to prevent back flow


Medium veins
Thin tunica intima and media but thick tunica adventitia

medium vein with valve

Medium Vein with valve
Irregularly dispersed smooth muscle
No internal elastic lamellae
Valves are the extensions of tunica intima to break into small compartments for movement (skinny extensions in photo)
Large veins are:
Tunica adventitia is thickest layer
Bundles of collagen and smooth muscle
May have vasa vasorum
Vena Cava, Portal vein

Large vein
vena cava
Thin tunica intima = ss. Tunic media = dispersed smooth muscle + CT

Granulocyte are:
Granulocytes
Neutrophils
Leukocyte
nucleus has small lobes 3-5 connected by filaments
Darkly stained nucleus light stained cytogranules
Smallest granulocyte
Eosinophils
rare
Larger than neutrophils
Bi-lobed nucleus visible among cyto granules
Prominent bright/orange granules, spectacle shape
Basophils
Least common
Violet or purple granules (Giemsa stain)
Nucleus often obscured by granules
Agranulocytes are
Agranulocytes
Lymphocytes
Smallest leukocyte
Round darkly stained round nucleus filling almost entire cell
Thin wall of cytoplasm visible as thin crescent
Monocytes
Largest leukocyte
Kidney shape nucleus, pale grey/light cytoplasm
Fairly large amount of cyto around nucleus
Other:
Platelets are the smallest, with no nucleus and blue cyto granules
Erythrocytes are medium small with no nucleus and no granules
neutrophil eosinophil b asophil
Neutrophils
Leukocyte
nucleus has small lobes 3-5 connected by filaments
Darkly stained nucleus light stained cytogranules
Smallest granulocyte
Eosinophils
rare
Larger than neutrophils
Bi-lobed nucleus visible among cyto granules
Prominent bright/orange granules, spectacle shape
Basophils
Least common
Violet or purple granules (Giemsa stain)
Nucleus often obscured by granules
lymphocytes and monocytes

Lymphocytes
Smallest leukocyte
Round darkly stained round nucleus filling almost entire cell
Thin wall of cytoplasm visible as thin crescent
Monocytes
Largest leukocyte
Kidney shape nucleus, pale grey/light cytoplasm
Fairly large amount of cyto around nucleus

neutrophils

eosinophils

basophils
lymphocytes

monocytes
blood key

Kidney
Kidney:
Remove metabolic waste, foreign chemicals, regulate salt concentrations, and maintain blood volume and acid-base balance
Proximal convoluted tubule and thick descending limb have cuboidal epithelium with a brush border (microvilli)
Thin segments have either low cuboidal or simple squamous epithelium (look similar to capillaries or small veins)
Thick ascending limb and distal convoluted tubules are lined with cuboidal epithelium without a brush border
Renal medulla contains segments of medullary pyramids. The apex points to the hilum.
Medullary rays extend from base of pyramid to cortex
Renal corpuscle consisting of glomerulus surrounding bowmans capsule.

Kidney
Outer cortex
And inner medullary region
Renal pyramid, point/peak at renal papillae where urine drips out

kidney:
Cortical tissue
Proximal distal convoluted tubules
Medullary rays and renal corpuscles
Outer renal cortex contains:
Renal corpuscle (macula densa)
Distal and proximal convoluted tubules
Medullary rays


kidney
Stripes are medullary rays (extensions of medullary projecting towards edge)
Collecting ducts and loop of henle
In between are cortical tissue


kidney;
Renal corpuscles are the onion shapes
Tubules surround it
Distal convoluted tubules clearer lumen (cuboidal)
Proximal convoluted tubules have brush border (cuboidal epi)
Distal convuluted vs proximal convuluted tubules in kidney
Distal convoluted tubules clearer lumen (cuboidal)
thin ascending to thick ascending
Proximal convoluted tubules have brush border (cuboidal epi)
thick descending to thin descending
Thin segments have either low cuboidal or simple squamous epithelium (look similar to capillaries or small veins)
Thick ascending limb and distal convoluted tubules are lined with cuboidal epithelium without a brush border

kdieny renal corpuscle
Outer parietal layer of bowmans capsule of ss

Ureter
Urine from kidney to urinary bladder
Folded lumen (star shape)
Inner mucosa composed of transitional epithelium on lamina propria
Muscularis layer contains 2-3 layers of smooth muscle
Thin inner longitudinal
Large circular muscle fibers ringing ureter
Adventitia lies outside muscularis layer and is coated with a serosa

Ureter
star shaped lumen, well developed muscularis layer

Ureter
star shaped lumen, well developed muscularis layer
Transitional epithelium
Surface cells (umbrella cells)
Underlying layer of LCT and muscularis layer

Ureter
star shaped lumen, well developed muscularis layer
Muscularis layer:
Thin inner band of longitudinal parallel to ureter
Large layer of circular muscle fibers
Longitudinal layer of smooth muscle
outer layer of serosa surruonding adipose tissue

Urinary bladder
Lumen is larger and muscularis is thicker than ureter
Three distinct layers
Inner and outer longitudinal layer
Separated by a middle circular muscle layer

Urinary bladder
Mucosa, muscularis, serosa


Urinary Bladder, Transitional epithelium on upper surface

urinary bladder
Three distinct layers
Inner and outer longitudinal layer
Separated by a middle circular muscle layer
Endocrine glands
Endocrine Glands (lack ducts, hormones are released into the blood or lymphatic circulation)
pituitary, thyroid, parathyroid

Pituitary gland (anterior pituitary ais lower end)

Hypophysis (PITUITARY GLAND)
Part of the brain composed of:
Anterior pituitary (adenohypophysis)
Pars distalis (anterior)
Pars tuberalis
Pars intermedia
Cells:
Large round acidophils (orange)
Basophils blue to purple general larger
Chromophobes weakly stained
Pars Intemedia
Between anterior and posterior pituitary
Fluid filled vesicles
Posterior Pituitary
Unmyelinated nerve axons and endings originating in hypo
Near capillary beds
Oxytocin and vasopressin is released and appear as pink masses called herring bodies

Hypophysis (PITUITARY GLAND)
Part of the brain composed of:
Anterior pituitary (adenohypophysis)
Pars distalis (anterior)
Pars tuberalis
Pars intermedia
Cells:
Large round acidophils (orange)
Basophils blue to purple general larger
Chromophobes weakly stained
Pars Intemedia
Between anterior and posterior pituitary
Fluid filled vesicles
Posterior Pituitary
Unmyelinated nerve axons and endings originating in hypo
Near capillary beds
Oxytocin and vasopressin is released and appear as pink masses called herring bodies

Pituitary
Thyroid
Produces, stores, and releases thyroid hormone
Sphericle follicesl lined with cuboidal follicular cells
Contains parafollicular cells (C-cells) in CT secreting calcitonin and don’t extend into the follicular lumen

Thyroid
Para follicular cells - secrete calcitonin (don’t extend into lumen), exist between follicular cells
Produces, stores, and releases thyroid hormone
Sphericle follicesl lined with cuboidal follicular cells
Contains parafollicular cells (C-cells) in CT secreting calcitonin and don’t extend into the follicular lumen

thyroid follicular and parafollicular cells
Produces, stores, and releases thyroid hormone
Sphericle follicesl lined with cuboidal follicular cells
Contains parafollicular cells (C-cells) in CT secreting calcitonin and don’t extend into the follicular lumen

Parathryroid:
Composed of glandular cells:
Chief Cells:
Most common, small dark nuclei, pale cytoplasm
Secrete parathyroid hormone (PTH)
Oxyphil cells:
Larger, fewer, eosinophilic cytoplasm.
Unkown function


Parathryroid:
Composed of glandular cells:
Chief Cells top:
Most common, small dark nuclei, pale cytoplasm
Secrete parathyroid hormone (PTH)
Oxyphil cells bottom:
Larger, fewer, eosinophilic cytoplasm.
Unkown function

Adrenal:
Two endocrine glands
Outer Cortex- secretes corticoids
Inner medulla - secretes catecholamines under NS control
Surrounded by CT capsule contain BV and nerve fibers

Secretory cells form cords divided into 3 layers
Outer glomerulosa (zona glomerulosa) secreting mineral corticoids
Middle fasciculate (zona fasciculate)
Deep reticularis (zona reticularis) produce cortisol
Composed of large round chomaffin cells arranged in short cords or clumps. Many capillaries viens and nerve fibers ‘

Adrenal:
Two endocrine glands
Outer Cortex- secretes corticoids
Inner medulla - secretes catecholamines under NS control
Surrounded by CT capsule contain BV and nerve fibers
Secretory cells form cords divided into 3 layers
Outer glomerulosa (zona glomerulosa) secreting mineral corticoids
Middle fasciculate (zona fasciculate)
Deep reticularis (zona reticularis) produce cortisol

3 zones of the:
Adrenal:
Two endocrine glands
Outer Cortex- secretes corticoids
Inner medulla - secretes catecholamines under NS control
Surrounded by CT capsule contain BV and nerve fibers
Secretory cells form cords divided into 3 layers
Outer glomerulosa (zona glomerulosa) secreting mineral corticoids
Middle fasciculate (zona fasciculate)
Deep reticularis (zona reticularis) produce cortisol
Exocrine Glands
Secretions by duct systems opening at surface of body. Glands are buried deeper, but excrete on the outside

Salivary glands
all have DIRC, all have septa dividing glands into lobules
Salivary:
Salivary:
Three major glands:
Parotid
Submandibular
Sublingual
Surrounded by a capsule, divded by septa (lobesa dn lobules)
Basic secretory unit: Salivon
Acinus
Serous (prot secreting). Pyramid shape
or mucous secreting cells
intercalated duct
Simple cuboidal
Becoming simple columnar when joined with excretory duct
Central nuclei and basal infoldings
excretory duct
Carry salivary products from stirated ducts to oral cavity
Epithelium depends on diameter
Small duct:
Simple cuboidal → pseudostratified columnar or stratified columnar
Large duct:
Stratifed columnar or stratified squamous are present

Parotid Salivary gland:
ALL Serous
Round basaly located nuclei
Striated duct visible below
Duct with stirations, representing basal infoldings

Submamdibular - mostly Serous salivary gland

Mucous acini are pale staining (cursor) salivary gland

Sublingual mostly mucous salivary gland
Mammary Gland:
Mammary Gland:
Ducts with cuboidal or columnar epitelia
Embedded in CT
Lymphocytes and myoeptihelial cells

mammary gland
Sweat Gland:
Tubular coiled glands
Salivons = secretory units
Clear cells - contain glyocgen
Dark cells
Myoepithelila cells
Ducts in cross ection have stratified cuboidal and no myoepithelial cells
Apocrine glands appear near follicles in the skin
And have largel umens
Simple cuboidal or columnar epithelial






Lymph nodes
Small bean shaped lymphati organs found along lymphatic vessels
Contain lymphocytes aiding in fighting infection
Near blood stream

Lymph nodes
Small bean shaped lymphati organs found along lymphatic vessels
Contain lymphocytes aiding in fighting infection
Near blood stream


Lymph node

Palatine tonsil
Guard the opening to the gastrointestinal and respiratory systems
Luminal surface = SS projecting deep into tonsil forming crypts
Crypts lined with lymphoid tissue and lympoid nodules

Palatine tonsil
Guard the opening to the gastrointestinal and respiratory systems
Luminal surface = SS projecting deep into tonsil forming crypts
Crypts lined with lymphoid tissue and lympoid nodules

Thymus
Maturation and proliferation of lymphocytes
Surrounded by CT capsule
Several lobes separated by CT septa
Each lobe has dense cortex and inner paler medulla
Hassalls or thymic corpuscles
Flattened epithelial reticular cells in concentric layers


Thymus
Maturation and proliferation of lymphocytes
Surrounded by CT capsule
Several lobes separated by CT septa
Each lobe has dense cortex and inner paler medulla
Hassalls or thymic corpuscles
Flattened epithelial reticular cells in concentric layers




Spleen
Filters blood
Surrounded by dense CT capsule with trabeculae penetrating the itssue (network of reticular cells and fibers)
White pulp (DARKER)
Lymphoid tissue (central artery)
Periarterial lymphatic sheaths (PALS) surround it
red pulp (LIGHTER)
Contains splenic sinuses and splenic cords. Containing blood cells, macrophages, and reticular cells.

Spleen WHITE PULP
Filters blood
Surrounded by dense CT capsule with trabeculae penetrating the itssue (network of reticular cells and fibers)
White pulp (DARKER)
Lymphoid tissue (central artery)
Periarterial lymphatic sheaths (PALS) surround it
red pulp (LIGHTER)
Contains splenic sinuses and splenic cords. Containing blood cells, macrophages, and reticular cells.
Spleen PALS
Filters blood
Surrounded by dense CT capsule with trabeculae penetrating the itssue (network of reticular cells and fibers)
White pulp (DARKER)
Lymphoid tissue (central artery)
Periarterial lymphatic sheaths (PALS) surround it
red pulp (LIGHTER)
Contains splenic sinuses and splenic cords. Containing blood cells, macrophages, and reticular cells.

Spleen RED PULP
Filters blood
Surrounded by dense CT capsule with trabeculae penetrating the itssue (network of reticular cells and fibers)
White pulp (DARKER)
Lymphoid tissue (central artery)
Periarterial lymphatic sheaths (PALS) surround it
red pulp (LIGHTER)
Contains splenic sinuses and splenic cords. Containing blood cells, macrophages, and reticular cells.

Spleen SPLENIC SINUSES
White pulp (DARKER)
Lymphoid tissue (central artery)
Periarterial lymphatic sheaths (PALS) surround it
red pulp (LIGHTER)
Contains splenic sinuses and splenic cords. Containing blood cells, macrophages, and reticular cells.
Filters blood
Surrounded by dense CT capsule with trabeculae penetrating the itssue (network of reticular cells and fibers)

Spleen
White pulp (DARKER)
Lymphoid tissue (central artery)
Periarterial lymphatic sheaths (PALS) surround it
red pulp (LIGHTER)
Contains splenic sinuses and splenic cords. Containing blood cells, macrophages, and reticular cells.
Filters blood
Surrounded by dense CT capsule with trabeculae penetrating the itssue (network of reticular cells and fibers)


Lymphatic tissue and nodules
PEYES PATCH IN ILEUM
Distributed along respiratory and gastrointestinal tract as lymphocytes or lymphatic nodules
Peyers patches in ileum of small intestine

OVARY: Outer cortex, containing follicles at varying stages
Inner medullary region, ovarian artery and veins

simple cuboidal on ovarian surface epithelium in outer cortex
Has basement membrane and DIRCT below as tunica albuginea
Corcles are follicles at varying stages of development
Cortex contains follicles